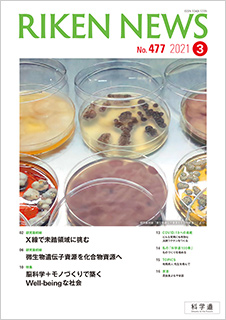

理研ニュース2021年3月号
理研ニュース2021年3月号
『理研ニュース』2021年3月号を本日発行しました。
「研究最前線」では、X線と微生物をキーワードに二つの研究を紹介します。一つは多くの物質を透過する性質からレントゲンなどに利用されてきたX線に関して、新しい特性の発見とその活用に挑戦する研究。そして、もう一つはペニシリンからイベルメクチンまで、つくりだした化合物で人類に数々の貢献をしてきた微生物をテーマに、「化合物資源」という視点でさらなる可能性を探る研究です。
「特集」では、理研の脳神経科学研究センターとトヨタ自動車株式会社の連携を紹介し、脳科学と技術の統合によって生み出される未来社会について語ります。
ぜひご覧ください。
